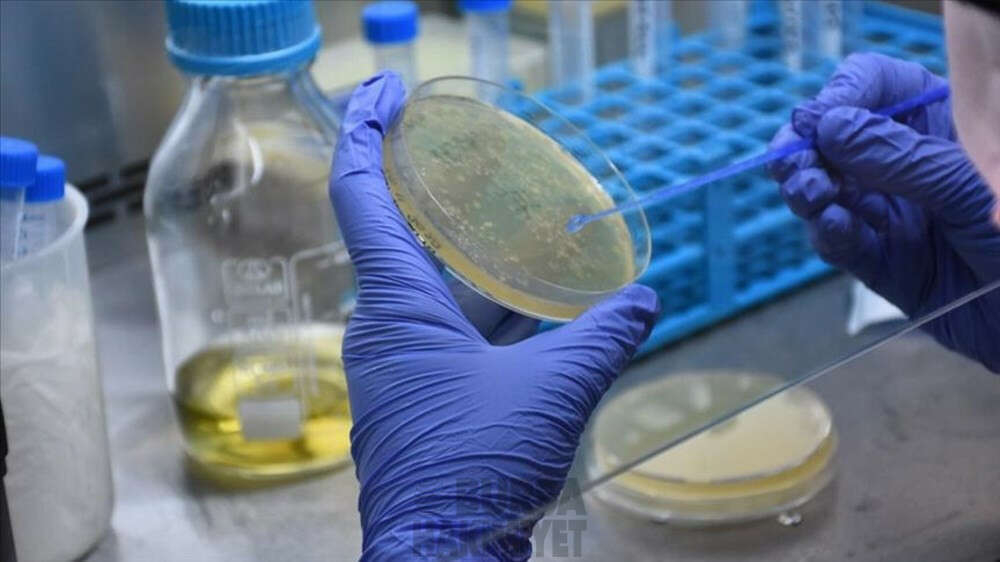

Korona krizinin ardından umut veren 17 teknoloji!
Yeni tip koronavirüs (Kovid-19) salgınının sağlık ve ekonomideki etkileri yıkıcı olurken, salgının teknolojide ilerlemeyi hızlandırdığı ve dijital araçların kabulünü artırdığı belirtiliyor. Kovid-19 krizinin ardından yılın umut veren 17 teknoloji trendi...
Oluşturulma Tarihi: 25 Ocak 2021, Pazartesi 12:17
YARI İLETKENLER: Yeni süper çipler: İşlemciler her bilgisayarın beynini oluştururken, teknoloji şirketleri arasında kendi çip tasarımını ve süper çip geliştirme rekabeti hızlanıyor. Amazon ve Microsoft, devasa veri merkezlerindeki sunucular için kendi yarı iletkenlerini geliştirirken, yıllardır çip endüstrisinin en büyük müşterisi olan Apple, şimdi en büyük yarı iletken üreticilerinden biri olmaya hazırlanıyor. Sağlık için giyilebilir elektronikten araç içi elektronik sistemlere kadar teknolojinin her alanında büyük önem taşıyan çipler, ülkeler arasındaki rekabet unsurlarından biri haline dönüşüyor. Pazarda hakimiyet oluşturmak isteyen şirketler ve ülkeler, devasa yatırımlarla çip endüstrisini şekillendirmeye çalışıyor.
PROTEİNLERİN YAPILARI ORTAYA ÇIKARILIYOR: Google'ın yan kuruluşlarından DeepMind'ın protein araştırmalarına yardımcı olmak için geliştirdiği AlphaFold isimli aracın proteinlerdeki "katlanma" sorununa dair önemli gelişmeler kaydetmesi dikkati çekmişti. 170 bin kodu çözülen protein yapısının bulunduğu bir veri tabanı donatılan AlphaFold, hatalı çalışan ve yapıları (kodları) çözülemeyen proteinlerdeki "katlanma" sorununa net veriler ortaya çıkardı. Sağlık sektörü, yapay zeka ile büyük verimlilik artışıyla karşı karşıya bulunuyor. Yapay zeka, hastalıkları daha hızlı teşhis etmeye, ilaç geliştirmeye veya tedavileri daha bireysel tasarlamaya giderek daha fazla yardımcı oluyor. Danışmanlık şirketi Accenture, sağlık hizmetlerinde yapay zeka kullanımıyla 2026'ya kadar yıllık 123 milyar avro tasarruf edileceğini tahmin ediyor.
UZAYDAN İNTERNET: Nesnelerin interneti, otonom sürüş veya makine iletişimi için dünyanın her yerinde hızlı ve güvenilir internete ihtiyaç duyulurken, hızlı internet bağlantısının uzaydan sağlanmasına yönelik girişimlerde artıyor. ABD bankası Morgan Stanley'in tahminlerine göre, 2040'e kadar "uydu genişbant" pazarının cirosu 3,9 milyar dolardan 95 milyar dolara yükselecek.
LABORATUVAR DIŞINDA KUANTUM BİLGİSAYAR: Uzun süren araştırmalardan sonra kuantum bilgisayarlar yavaş yavaş laboratuvarlardan ayrılıyor. Daha fazla şirket kuantum bilgisayarlarının iş dünyasında kullanım potansiyellerini belirlemeye çalışıyor. Kuantum bilgisayarların gelişiminin henüz emekleme aşamasında olduğunu belirten uzmanlar, bu yıl ilerlemenin hızlanmasını bekliyor. Az enerji kullanan ve devasa depolama kapasitelerine sahip hızlı kuantum çiplerinin yakında geliştirilmesi beklenirken, kuantum teknolojisinin potansiyeli giderek daha fazla yatırımcının dikkatini çekiyor.
OTONOM SÜRÜŞ: Otomobil üreticileri Seviye 3 otonom sürüş özelliğine sahip araçları pazara sürmeye hazırlanırken, bunun sürücülere otoyolda uzun ve yorucu yolculuklarda yardımcı olması bekleniyor. Otonom sürüşte, otomasyon derecesi seviyelere göre (0 ile 5 arasında) değişirken, mevcut teknoloji ikinci seviyede bulunuyor.
GİYİLEBİLİR TEKNOLOJİLER: Konuşma ve metin tanıma gibi iyileştirilmiş yapay zeka algoritmaları, 5G ve daha güçlü kulaklıkların gerçek zamanlı çeviriyi yakında sağlaması beklenirken, Çinli start-up Timekettle Technologies şimdiden mikrofon ve akıllı telefon uygulamasıyla yaklaşık 40 dili çevirebilen kablosuz kulaklıklar satıyor. Trend, giyilebilir cihazların tıbbi faydaları nedeniyle de önemli ölçüde artacağına işaret ederken, Kovid-19'nun bu trendi bir üst seviyeye iteceği belirtiliyor.
CÜZDAN YERİNE AKILLI TELEFON: Dünyanın en büyük nüfusuna sahip olan Çin'de, Alipay ve WeChat Pay'de olduğu gibi günlük yaşamın bir parçası olan uygulama ile ödeme yapılması dikkati çekerken, Covid-19 ile dünyanın diğer ülkelerinde cüzdan yerine akıllı telefon vasıtasıyla ödeme yapmanın artması bekleniyor. Sosyal medya şirketleri Facebook ve WhatsApp, ödeme ve para transferi konusunda pazar oluşturmaya çalışırken, teknoloji şirketleri Apple ve Google bankalar ve kredi kartı şirketleriyle iş birliği yaparak bu hizmetleri sağlıyor.
SANAYİ 3D YAZICILARLA BÜYÜYOR: Modern 3D yazıcılarla son derece yenilikçi bir ürün mümkün olan en kısa sürede seri olarak üretilebiliyor. Covid-19 ile birlikte yerinde üretimin öneminin artması ve 3D yazıcı kullanımının ivme kazanması bekleniyor.
VERİLERLE HAYAT KURTARILIYOR: Dijital dosya, sağlık sektöründe dijital veri alışverişi için önemli hale gelirken, salgınla bu veri alış verişin hızlanması bekleniyor. Danışmanlık firması McKinsey tarafından yapılan hesaplamalara göre, bununla sağlık sigortacılığı sektöründe her yıl 34 milyar avro tasarruf edilecek. Covid-19'da "bir veri tabanı eksikliğinden" mustarip olan hükümetler ve şirketler verilere odaklanırken, uzmanlar standart bir veri alışverişi yoluyla hastaları, doktorları ve sağlık sisteminin önemli ölçüde rahatlayabileceğine işaret ediyor. Dijital aşı sertifikasının Covid-19'da tarihin en büyük aşı kampanyasına imkan sağladığına değinen uzmanlar, verilerin kullanılmasıyla hayatların kurutabileceğini vurguluyor.
İŞGÜCÜ PİYASASINDA HİPER OTOMASYON: Resesyon döneminde şirketler tasarruf etmek zorunda kalırken, bunun sonucu çalışanlar için acı bir gerçekliğe dönüşüyor. Çünkü şirketler otomasyona yatırım yapıyor. Covid-19 krizinde bazı tabular yıkılırken, şirketler üzerindeki yük de arttı. Fabrikalarda tekrar eden işler için robotik otomasyon süreçleri gündeme geldi. İş süreçlerinin artan dijitalleşmesi ve otomasyonu nedeniyle bazı iş rollerin ortadan kaldırılması bekleniyor.
SİBER GÜVENLİK: Covid-19 krizi nedeniyle, birçok şirket çalışanlarının işlerini, genellikle sistematik koruyucu önlemler almadan çalışanlarının ev ofislerine taşırken, siber saldırı riski arttı. Uzmanlar, Covid-19 salgınının siber suçluların ne kadar esnek ve uyarlanabilir olduklarını gösterdiğini belirterek, otomasyonun da dijital yeraltına indiğine işaret ediyor.
KONUŞAN MAKİNELER: Ofis çalışanları her hafta e-postalarını yazmak için saatler harcarken, artık konuşan programlarla zamandan tasarruf edilecek. Artık belgeler arasında gezinmek yerine belirli soruları bilgisayara yazarak, onların bize konuşarak cevap vermesi sağlanacak.
BULUT BİLİŞİM: Bulut bilgi işlem, ekonominin merkezinde yer alırken, düşük donanım maliyeti ve kullandıkça öde özelliği ile kurumlara önemli bir tasarruf imkanı sağlaması dikkati çekiyor. Bulut bilgi işlem piyasasının 2023 yılına kadar ortalama yüzde 22 büyüyerek 500 milyar dolara ulaşması bekleniyor. Dijitalleşmede Alibaba, Amazon gibi Çin ve ABD merkezli tedarikçilere bağımlılığı azaltmak amacıyla Avrupa'da bulut ağı (Giaa X) kurulma çalışmaları devam ediyor.
BİYOTEKNOLOJİ: mRNA olarak adlandırılan haberci nükleik asitlere dayanan iki Covid-19 aşısının başarılı bir şekilde geliştirilmesi, aniden mRNA aktif bileşenlerine ilgiyi artırdı. Uzmanlar, mRNA'nın yalnızca aşı geliştirmede değil, diğer ilaçlarda da yeni bir dönem başlatacağını belirterek, ilaçların geliştirilmesinin daha hızlanacağına ve daha kolay üretileceğine işaret ediyor.
MOBİLDE GERÇEK ZAMANLI İLETİŞİM: Akıllı telefon üreticileri ilk 5G özellikli akıllı telefonunu piyasaya sürerken, ağ operatörleri de mobil iletişim standardını genişletiyor. Daha yüksek hız sağlayan 5G teknolojisi, neredeyse gerçek zamanlı veri aktarımı vadediyor.
ARTIRILMIŞ GERÇEKLİK: Kovid-19 salgını ile e-ticaret yükseliş yaşarken, artırılmış gerçeklikle müşterilerin birçok ürünü sanal olarak denemesi ve yerleştirmesi sağlanıyor. Örneğin gözlük alırken müşteri gözlüğü dijital olarak denenebilecek. Müşteriler eski mobilyaları bir kenara bırakmadan oturma odasına sanal olarak bir koltuk getirebilecek.
UZAYA SEYAHAT YARIŞI: SpaceX ve Space Adventures, ilk turistleri uzay yolculuğuna göndermeye hazırlanırken, yeni teknolojilerle uydu taşımacılığı maliyetlerinin 3-5 kat azaltılarak kilo başına 10 bin avroya düşürülmesi hedefleniyor.
SON GALERİLER
-

-

-

-

-

-

-

-

-

-